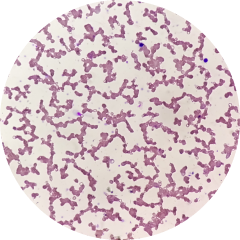

Dietary Supplement Product - SW Probiotics Women’s Balance
New generation probiotic with specially cultured mono strains of Lactobacillus acidophilus LA-14® and Lacticaseibacillus rhamnosus HN001™ (HOWARU® Rhamnosus): Restoration of the balance of vaginal microflora in women, enhancement of local immunity and protection against infections.
Item number: 501515
Best before: 11/10/27
Remain: 100+ pcs.
590 ฿
16.9 pts.
- Pickup: , at points

Support for women's health
Promotes increased resistance of the mucosa of the urogenital system to pathogenic flora.

Clinically proven
Proven action in the prevention and therapy of bacterial vaginosis.

Maximum effectiveness
Active strains resistant to the acidic environment of the stomach.

Suitable for vegetarians
DR plant-based, delayed-release capsules designed for targeted action in the intestine.
Under the reliable protection of Siberian Wellness Probiotics
Enjoy life without discomfort in the genital area!
The microbiota of the genital area in women has a distinct microbiological composition. Daily stress, dietary restrictions, and natural age-related processes, along with changes in hormonal balance, can disrupt its balance and serve as the starting point for the deterioration of overall health and reduced quality of life.
The most common and unpleasant form of vaginal dysbiosis is bacterial vaginosis, characterized by a decrease in normal microflora and a significant increase in harmful pathogenic bacteria. It is the most common problem among women aged 18–45. Between 20% to 50% of women of childbearing age can experience bacterial vaginosis, with half of the cases being asymptomatic. Its prolonged course can lead to increased susceptibility to infections (including candidiasis), dysplasia, and even infertility.
Taking Women's Balance probiotic complex with specially cultured strains helps increase the number of lactobacilli in the genital area and promote harmony in the vaginal microbiome, thereby preventing the development of dysbiosis and inflammation¹.
Enjoy life without worrying about problems!
A new generation of probiotics

Especially for women
Mono strains of Lactobacillus acidophilus LA-14® and Lacticaseibacillus rhamnosus HN001™ are part of the normal vaginal and intestinal microflora.
Women's Balance consists of a combination of Lactobacillus acidophilus La-14® and Lacticaseibacillus rhamnosus HN001™ (HOWARU® Rhamnosus) strains, which survive in the digestive system and effectively colonize the genital area².
• Promotes colonization upon oral administration.
• Reduces the harm caused by vaginal pathogens.
• Improves local and systemic immune response.
Specially cultured strains exhibit antimicrobial activity by acidifying the vaginal pH and stimulating the production of hydrogen peroxide. Additionally, vaginal probiotics are expected to adhere to vaginal epithelial cells, thus preventing the introduction of potential pathogens³. The LA-14 and HN001 strains enhance local and systemic immunity, boosting the body's defenses against pathogens and infectious agents.
For whom?
For women to maintain a healthy vaginal environment on a regular basis.
2
mono strains
Lactobacillus L. acidophilus and L. rhamnosus are part of the normal microflora of the vaginal area in women.
5х10⁹
CFU of lactobacilli
Effective dosage with clinically proven action.
Ingredients
Composition of the final product (in 1 capsule (600 mg)):
Active Ingredients:
Fructooligosaccharides powder (100%) 429,9 mg
Lactobacillus acidophilus 60 mg
Lactobacilli Rhamnosus 6,6 mg
Inactive Ingredients:
Hydroxypropyl methylcellulose 95 mg
Gellan gum 5 mg
Silica 3,5 mg
Directions for use
Adults take 1 capsule daily with a meal. Course duration: 15 days. If necessary, the course can be repeated.
Reviews